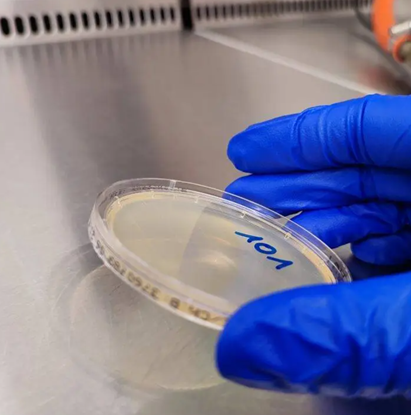

Puhtausnäytteenoton haasteet
Säännölliset pintapuhtausnäytteenotot ovat arkipäivää elintarvikealan toimijoille. Pintapuhtausnäytteenottoja käytetään varmistamaan yleistä elintarvikehygieniaa ja näytteenottosuunnitelma on usein osa yrityksen omavalvontasuunnitelmaa. Näytteet tulee ottaa näytteenottoon koulutettu henkilö, joka ymmärtää näytteenottojen mahdollisuudet, mutta myös sen miten virheitä syntyy ja mitä näytteen tulos ei kerro.
Elintarvikealalla käytetään yleisesti kahta eri menetelmää pintapuhtauden analysoinnissa. Toinen menetelmistä on niin sanottu sipaisunäyte, eli näytepuikolla pintaa pyyhkimällä otettu näyte. Pinnan pyyhkimisen jälkeen näytepuikko asetetaan näyteputkeen. Näyteputkessa näyte reagoi reagenssien kanssa, mistä syntyy kemiallinen reaktio. Mittaus perustuu reaktion havaitsemiseen, usein luminometrisesti. Se tarkoittaa, että reaktio tuottaa valoa ja mittauksessa mitataan havaittua valon määrää. Yleisin pintapyyhkäisytesti on ATP-mittaus, jossa mitataan ATP:n eli adenosiinitrifosfaatin (eng. adenosine triphosphate) määrää näytteessä. ATP on universaali solujen energia-aineenvaihduntaan liittyvä molekyyli. ATP hajoaa kemiallisessa reaktiossa, mikä vapauttaa energiaa valon muodossa. Valo havaitaan luminometrillä; luminometri on laite, joka on rakennettu havaitsemaan pieniä määriä valoa.
Toinen pintapuhtauden analysoimisessa käytetty menetelmä on perinteinen mikrobiologinen viljely (havainnollistava kuva 1). Mikrobiologisessa viljelyssä mikrobit kasvavat petrimaljalla geelimäisessä elatusaineessa yleensä 1–3 päivää, minkä jälkeen voidaan havaita mitä mikrobeja maljalla kasvaa. Viljely voidaan tehdä kontaktimaljamenetelmällä, jossa petrimalja on täytetty elatusaineella kukkuralleen, minkä jälkeen elatusaineen annetaan jähmettyä geeliksi. Kun näyte halutaan ottaa, malja painetaan tutkittavaa pintaa vasten siten, että pinnalla olevat mikrobit painautuvat geeliä vasten ja jäävät elatusaineen pinnalle. Sen jälkeen malja suljetaan ja viedään kasvatukseen. Elatusaineessa mahdolliset pinnalta siirtyvät mikrobit alkavat jakaantumaan muodostaen pesäkkeitä. Viljely voidaan myös tehdä erillisellä kasvualustalla, muun muassa Hygicult on valmis levy, jossa on valmiina elatusainetta. Levy voidaan painaa tutkittavaa pintaa vasten ja joko kasvattaa sellaisenaan sille tarkoitetussa astiassa korkki kiinni, tai levyltä voidaan siirtää siirrotussilmukalla näytettä petrimaljalle kasvatusta varten.
Kuva 1. Mikrobiologinen viljely. Lähde: Hygiene Nord, creative commons -käyttöluvat.
Näytteenottojen luotettavuus
Näytepuikolla otettu kemialliseen reaktioon perustuva pyyhkäisynäyte (käytännössä aina siis ATP-testi) antaa tuloksen välittömästi mittauksen jälkeen. Yhden näytteen ottaminen ja tuloksen saaminen vie kokonaisuudessaan muutaman minuutin. Koska mittauksessa mitataan ATP-molekyylin määrää, mikä on universaali molekyyli kaikissa soluissa, mittauksessa havaitaan ATP kaikista orgaanisista lähteistä. Tämä tarkoittaa, että mittaus ei erottele onko näytteessä eläviä vai kuolleita mikrobeja. Mittaus ei myöskään anna vastauksia siihen, minkä tyyppisiä mikrobeja näytteessä on ollut (bakteerit, sienet, eläinsolut jne.). Mikrobit voivat olla ihmiselle hyödyllisiä, neutraaleja tai tautia aiheuttavia eli patogeenisia. ATP-mittaus ei vastaa kysymykseen siitä, onko pinnalla ihmiselle haitallisia tai vaarallisia mikrobeja. ATP-mittaus kertoo vain, onko pinnalla eliöperäistä materiaalia, eli mikrobiologista likaa. ATP-mittauksella saadaan selville myös, paljonko likaa on.
ATP-mittauksia pidetään yleisesti luotettavina pikatesteinä kertomaan hygienian tasosta sellaisilla pinnoilla, joilla oletettavasti ei ole juuri lainkaan eliöperäistä materiaalia. ATP-mittauksia kannattaa siis ottaa esimerkiksi puhdistuksen tehokkuuden varmistamiseksi juuri pestyn tuotantolaitteen pinnalta tai vaikka keittiön puhtaista välineistä. ATP-mittausten kohdalla tulee kuitenkin olla realistiset odotukset siitä, minkälaisia tuloksia saadaan ja mitä tuloksista voi päätellä.
ATP-mittausten sijaan mikrobiologinen viljely on tarkka tapa selvittää, minkälaisia mikrobeja pinnalla on. Viljelyssä kasvavat vain elinkykyiset mikrobit ja mikrobit luovat kasvaessaan pesäkkeitä. Pesäkkeet voidaan tunnistaa, minkä lisäksi jatkoviljelyiden ja jatkokäsittelyiden avulla voidaan poissulkea tai varmistaa tietty bakteeri- tai sienilaji. Koska mikrobit voidaan tunnistaa suhteellisen pitkälle, voidaan selvittää myös patogeenien läsnäolo tutkittavalla pinnalla.
Mikrobiologisen viljelyn oleellisena haittapuolena on kuitenkin viljelyaika. Jos näyte otetaan pinnalta maanantaina, mutta kasvatus vaatii kolme päivää, tieto huonosta tuloksesta ei auta enää torstaina, kun mahdollisesti satojen ihmisten ruoka on voinut kontaminoitua kolme päivää sitten. Vaikka viljely antaa tarkempia tuloksia, se ei sovellu pintapuhtausnäytteeksi tilanteissa, missä mittauksesta tulee saada jonkinlainen tulos lyhyen aikavälin sisällä.
Mikrobiologisessa viljelyssä tulee ottaa huomioon se, että näytteenottajalla tulee olla jonkinlainen ymmärrys mikrobiviljelystä, vaikka itse viljelyn suorittaakin ammattilainen. Näytteessä olevat mikrobit voidaan väärällä toiminnalla myös tappaa, jolloin viljelystä voi tulla valheellinen tulos. Valheellinen tulos voi vaarantaa elintarviketurvallisuuden, sillä silloin tieto kontaminaatiosta ei välity työntekijöille ja elintarvikkeet siirtyvät eteenpäin jakeluketjussa.
Tällä hetkellä ei ole luotettavaa pintapuhtaustestiä, joka tunnistaisi mikrobeja ja antaisi tuloksen välittömästi. Tämän vuoksi esimerkiksi elintarviketuotannossa olisi suotavaa yhdistää useita erilaisia pintapuhtauden seurannan menetelmiä. Sen lisäksi, että tiloissa tulee tehdä jatkuvaa aistinvaraista puhtauden arviointia, laitteista ja välineistä kannattaa ottaa pintapuhtausnäytteet pesun jälkeen ja pinnoilta kannattaa säännöllisesti tehdä myös viljely. Kun menetelmiä käytetään rinnakkain, niistä saatu tieto tukee toisiaan. Se antaa kattavimman kuvan pintapuhtauden tasosta, sillä mikään puhtauden seurannan menetelmä ei yksinään pysty antamaan riittävää kokonaiskuvaa hygieniatasosta.
Näytteenotossa huomioitavia asioita
Sipaisunäytteessä näytteenotossa tulee noudattaa laitevalmistajan antamia näytteenotto-ohjeita. Ohjeet sisältävät usein tietoa näytteenottoalueen pinta-alasta, näytteenoton menetelmästä ja käytössä olevan mittauslaitteen käyttövaatimuksista. Näytetulokseen vaikuttaa pinnan epätasaisuus, pinnalla oleva kosteus, tutkittu pinta-ala ja se millä paineella ja voimalla näyte on otettu. Muun muassa märältä pinnalta otettu näyte antaa lähes aina virhetuloksen. Itse mittalaitteessa on laitekohtainen viritysaika ja laite tulee kalibroida ammattilaisella säännöllisin väliajoin. Laitetta tulee käyttää ja säilyttää oikeissa olosuhteissa.
ATP-mittauksissa näytepuikot saadaan samalta valmistajalta, kuin itse luminometri ja tulos saadaan laitevalmistajan antamassa yksikössä. Laitteiden ja laitevalmistajien välillä voi olla eroja mittaustulosten ja yksiköiden verrannollisuudessa, eli kahden eri laitteen antamaa tulosta ei voi verrata keskenään. Lisäksi tulos ei ole välttämättä suoraan verrannollinen näytteenottopinnalla olevaan solujen määrään, mikä tarkoittaa, että tulokselle saatetaan joutua tekemään jatkolaskelmia. Tulos on suoraan verrannollinen pinnalla olevien mikrobien tai pinnalla olevan ATP:n määrään vain, jos laitevalmistaja on kalibroinut laitteen olemaan verrannollinen siihen. Lisäksi laitevalmistajan antamat raja-arvot eri pinnoille ovat suuntaa antavat ja niitä voidaan ja täytyy muokata käyttötarkoitukseen sopivaksi, mikäli sille on tarvetta.
Näytteenottojen suunnittelussa huomioitavia asioita
Pintapuhtausnäytteenotto on suhteellisen kallista. Yksi pintapyyhkäisynäytepuikko maksaa noin 5–6 euroa riippuen siitä, miten hyvän tarjouksen myyjältä saa (Siivous.fi). Yksi HygiCult-levy maksaa myös noin 3–4 euroa kappaletta kohden (Penli Oy). Yhdestä puikosta saa yhden näytteen ja yhdestä HygiCult-levystä saa sellaisenaan tehtyä yhden kasvatuksen yhdeltä pinnalta. Näin ollen, jos näytteitä otetaan kerralla esimerkiksi viisi ja näytteitä otetaan esimerkiksi elintarviketuotannossa joka päivä, kustannukset kasvavat nopeasti. Etenkin pienemmällä tai aloittelevalla yrityksellä voi olla houkutteena käyttää vain yhtä pintanäytteenottomenetelmää. Olisi kuitenkin tärkeää, että menetelmiä käytetään rinnakkain tai ainakin käytetyn menetelmän heikkouksista ollaan tietoisia.
Lähteet:
Melenius M. (2026.) Puhtausnäytteenottopalvelun asiakaskohtaisen toteutuksen analyysi ja kehittämismallin laatiminen Diversey Suomi Oy:lle. Turun ammattikorkeakoulun opinnäytetyö.
Kuva 1. Hygiene Nord. (ei.pvm.) Hygiene controls. Haettu 22.4.2026 osoitteesta https://www.hygiene-nord.de/en/hygiene-controls/
Siivous.fi. (Ei pvm.) Hygiena UltraSnap reagenssitikut 25kpl/pkt HUS2020. Haettu 14.4.2026 osoitteesta https://www.siivous.fi/fi/tuote/tuotteet/keittiohygienia/hygieniatestit/8590/hygiena-ultrasnap-reagenssitikut-25kplpkt-hus2020
Penli Oy. HygiCult TPC. Haettu 14.4.2026 osoitteesta https://www.penli.fi/product/1200/hygicult-tpc?gad_source=1&gad_campaignid=18007661971&gbraid=0AAAAADECjmKQOtZink8YvUhWoirp1kWLK&gclid=Cj0KCQjwy_fOBhC6ARIsAHKFB7-noAxqcKJKG3R4C3dqTSD-y0HzXGBaze49BbjwxmdFxMgqg4ROi-waAvn0EALw_wcB